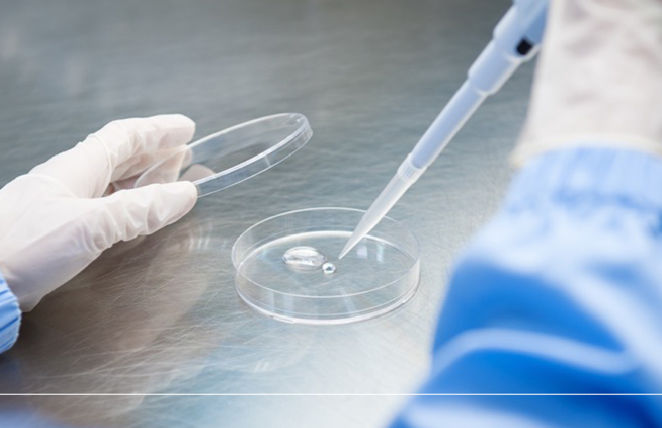

Hakubaku´sBaby Foods-Safe & Gentle for Babies-
Hakubaku’s Commitment to Baby Food
Products Made with Simple,
Natural Ingredients
Our baby food is grain-based and made only with simple, naturally derived ingredients, without using any food additives. We want to offer products that are safe and reliable for children, and hope that they will grow up healthy with the power of nature. With these wishes in mind, Hakubaku supports both parents and children.

Food Safety Initiatives
Hakubaku is a company that has been handling grains for over 80 years. Our products are of high quality, thanks to the many improvements we have made throughout our long history. Their high quality and safety have been recognized by external organizations, as evidenced by the various certifications we have obtained.

Our Commitment to Ingredient Quality and Safety
Non-GMO Ingredients
We are committed to providing safe food for your little one. That’s why we do not use any genetically modified ingredients in our products. In particular, for soybeans and corn, we exclusively use identity-preserved (IP-handled) ingredients to ensure that there is no mixing with genetically modified crops at any stage.

Pesticide Residue Screening
To protect your baby’s health, we conduct thorough pesticide residue testing on all raw materials, whether sourced domestically or imported. Every batch is checked not only for pesticides used during cultivation but also screened for a wide variety of possible residues. Only ingredients that fully pass our strict standards make it into our products, ensuring safety and quality you can trust.

Strict Monitoring for Radioactive Substances
Since April 1, 2012, Japan has enforced strict standards for radioactive substances in foods for infants (100 Bq/kg for general foods, 50 Bq/kg for infant foods, set by the Ministry of Health, Labour and Welfare).
Hakubaku Baby Noodles products are labeled as “Infant Standards Applied Food,” proving they meet Japan’s rigorous safety requirements.
Products

Point 1
Non-Fried Method,
No Salt or Sugar Added

Since this product is made using a non-fried method, no oil is used in the manufacturing process. Additionally, it is not flavored with salt or sugar, allowing you to enjoy the natural, gentle taste of the ingredients themselves.
Because it is made only from simple, naturally derived ingredients, it is also safe for babies.
Point 2
Easily Dissolves in the Mouth—
Perfect for Practicing Self-Feeding

With its light and crispy texture, this product easily dissolves in the mouth, allowing babies to eat it as it gradually softens. Its round shape makes it easy to grasp, and because it doesn’t make hands sticky, it is perfect for practicing self-feeding.
Point 3
Enjoy as Much as You Want,
Whenever You Want

The resealable bag makes it easy to store and allows you to take out just the amount you want whenever you wish to eat. This snack is perfect not only for enjoying at home, but also as a convenient treat to take with you when you’re on the go.
7+ Months

Baby Cereal Puffs with Natural Fiber
Basic Product Information
| Net Weight | 15g |
|---|---|
| Ingredients | Cracked corn, Barley flour |
| Best Before | 540 days |

Baby Cereal Puffs with Natural Protein
Basic Product Information
| Net Weight | 15g |
|---|---|
| Ingredients | Cracked corn, Barley flour, Pea protein |
| Best Before | 540 days |

Point 1
No Salt or Seasonings Added—
Made Only from Barley

No salt or seasonings are added, and barley is the sole ingredient, allowing you to enjoy the gentle sweetness naturally derived from the grain.
*This product does not contain rice.
Point 2
Easy to Prepare in the Microwave

This product can be prepared not only in a small pot but also in the microwave. Because the barley is thinly processed, it cooks quickly—in about 2 minutes in the microwave.
Point 3
Dietary Fiber from Barley

Barley, which is rich in dietary fiber, is the only ingredient used. You can enjoy this product on its own, or easily increase your dietary fiber intake by adding the cooked barley to rice porridge.
7+ Months

Baby Barley Flakes for Porridge
Basic Product Information
| Net Weight | 120g |
|---|---|
| Ingredients | Barley |
| Best Before | 540 days |
Microwave Cooking Instructions
- Place the product and water into a microwave-safe container.
- Do not cover with plastic wrap.
- Heat at 500-600W.

| Amount of Barley | 5g | 10g | 15g |
|---|---|---|---|
| Amount of Water | 50ml | 70ml | 90ml |
| Final Weight | 17g | 34g | 54g |
| Cooking Time | 1min | 1min 30sec | 2min |
Notes:
- Use a deep, microwave-safe bowl (about the size of a regular donburi bowl).
- Be aware that the contents may boil over during heating.
- The bowl will become very hot after microwaving, so handle with care.

Point 1
Naturally Caffeine-Free

Barley tea is a naturally caffeine-free beverage. This makes it ideal not only for children, but also for mothers to stay hydrated during pregnancy and breastfeeding.
Point 2
Zero Calories—
Perfect for Hydration

Barley tea is a zero-calorie beverage, making it perfect for hydration. You can enjoy the natural sweetness of barley itself without adding any sugar or milk. It’s an ideal drink for the whole family that you can enjoy freely, without worrying about calorie intake.
Point 3
100% Japanese Barley—
Gentle Flavor

Hakubaku’s barley tea is made exclusively from Japanese-grown barley. To create a taste suitable for children who are sensitive to bitterness, the manufacturing method has been improved many times, resulting in a barley tea with reduced bitterness and a gentle sweetness that everyone can enjoy.
5+ Months

Mild Barley Tea for Children
Basic Product Information
| Net Weight | 416g(52 bags), 160g(20 bags) |
|---|---|
| Ingredients | Roasted barley |
| Best Before | 540 days |
| Boiling Time | HOT and COLD brew |
Basic Barley tea Recipe
HOT BREW
- Bring 1.5 liters of water to a boil in a kettle or similar container.
- Once boiling, turn off the heat and add the Barley tea bags.
- After about 1 hour, remove the Barley tea bag and transfer to another container.
- It can be served cold or hot.
- It has a refreshing taste with little clutter.
COLD BREW
- Place one barley tea bag in a pot with 1 liter of cold water and put it in the refrigerator.
- After about 2 hours (once the water has cooled), remove the barley tea bag.
- Barley tea does not easily become bitter, even if the tea bag is left in the water overnight.
- Soft water is recommended for brewing barley tea.
- Please refrigerate the prepared barley tea and consume it as soon as possible.
When Can Babies Start Drinking Barley tea?
Before starting solid foods, babies get all the nutrition and hydration they need from breast milk or infant formula.
Introducing other drinks too early may reduce the amount of milk your baby consumes. As a result, they could miss out on essential energy and nutrients.
We recommend offering barley tea around five to six months of age, when your baby begins eating solid foods.
(This recommendation is based on Japan’s Guidelines for Breastfeeding and Weaning, issued by the Ministry of Health, Labour and Welfare.)

Please contact us.
Please feel free to contact us at the
e-mail address below to request a quote or other information.
Our representative will reply to you within a few days.
We look forward to hearing from you about your OEM needs.
contact@hakubaku.com


